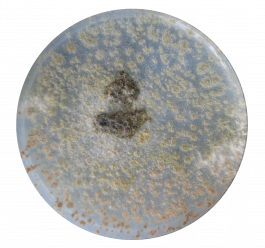
MARKUS SCHIEMANN

CAR-FREE JOHANNESSTRASSE
______________________
As a Starting Point for Social and Climatic Sustainability in Stuttgart’s Urban Space
This project aims to explore transformation strategies for a more climate- and socially resilient Stuttgart. A multi-layered design approach is developed that integrates ecological, social, and infrastructural dimensions.
At its core lies the reactivation of urban networks and cycles, approached both conceptually and through urban design. Participatory and integrative strategies define which spaces require new spatial programs and which can be appropriated by citizens themselves. Questions of co-creation and shared authorship are examined through the lens of urban (bio)diversity — asking:
Who are the city’s inhabitants? Who gets to decide? Who is able to participate?
This study explores the urban spatial potential that could be unlocked by reducing private motorized transport (PMT) in Stuttgart. Against the backdrop of increasing urbanization and climate-related challenges, the role of the automobile within the urban fabric is critically examined. The focus lies on three key areas of action:
urban climate, mobility, and public space.
Based on qualitative surveys, the study analyzes how the car and public space are perceived by Stuttgart’s residents. The findings reveal that PMT contributes significantly to spatial, social, and ecological shortcomings in the cityscape. Particularly evident are the excessive land consumption and the resulting fragmentation of public space. At the same time, the surveys reflect an ambivalent attitude: while many residents still depend on private vehicles, there is a strong interest in alternative mobility concepts—provided that infrastructure, especially public transport and cycling networks, is substantially improved.
Urban planning potential is identified in the reurbanization of traffic-dominated spaces, which can be reactivated through mixed-use development, shortened distances, and the reintegration of productive functions. The study concludes that reducing PMT is not only beneficial from a climate and transportation policy perspective but also presents a major opportunity to enhance urban liveability and redefine public space.
Mycelium as a Catalyst for a Car-Free, Climate Responsive City
On a technical and material level, the design proposes infrastructural interventions that support a car-free city, particularly through the unsealing of paved surfaces. A key element in this process is living mycelium, cultivated from native fungal species. As a renewable, locally producible material derived from regional waste streams, mycelium not only enables ecological regeneration but also offers a circular, sustainable alternative for building.
Its organic properties and formal adaptability make it a powerful mediator between the built environment and natural processes. By reclaiming sealed surfaces and reactivating urban climatic cycles, mycelium opens up new spatial and design strategies for transforming urban infrastructure. This hybrid approach merges ecology, material research, and urban design into a cohesive strategy that fosters a resilient and democratic public realm — one that interweaves ecological qualities with social needs and offers a potential pathway toward post-automobile urban development.

Context and Potential of Johannesstraße in Stuttgart-West
Johannesstraße, established around 1830 as Stuttgart’s first grand boulevard under King Wilhelm I, connects two key urban landmarks – Hölderlinplatz and Feuersee. Despite its historic character, defined by rows of linden trees and cobblestone paving, the street today is dominated by private vehicle use. Generously proportioned sidewalks and the spaces between the trees primarily serve as parking areas, leaving much of the street’s spatial and social potential underutilized.
Due to its exceptional width, central location in a densely populated district, and its function as a linear connector between two socially significant urban nodes, Johannesstraße offers ideal conditions for a transformation into a low-traffic or car-free public space. The existing vegetation provides a strong foundation for climate-responsive urban development and enhanced urban biodiversity. The high density of residents and frequent use of the street further support participatory planning processes with strong community engagement.
Within the broader urban fabric of Stuttgart-West, Johannesstraße functions as a potential development axis for new mobility and usage models. Its redesign presents an opportunity to create a prototypical public space that can serve as a catalyst for a more sustainable and livable city in the long term.






This project addresses the qualitative reactivation of public space along Johannesstraße, a street currently dominated by private motorized traffic and its associated infrastructure. The objective is to redefine the urban environment as a social, ecological, and multifunctional space.










Public Space
At the core of the project lies a more equitable redistribution and activation of public space to accommodate diverse uses. The street space is envisioned as a place of exchange, encounter, and communal life. Design strategies are informed by resident surveys to ensure that the heterogeneous needs of urban society are reflected in the spatial program. Special emphasis is placed on ground floor zones, which function as transitional spaces between public and private realms, and are reimagined as key interfaces for urban vibrancy.
Mobility
The project aims to transform Johannesstraße into a pedestrian-oriented corridor, aligning with the principles of a car-reduced urban structure. Improvements to walkability are supported by targeted infrastructural interventions and a dense network of public transportation. The overarching goal is to create a walkable urban environment that fosters social interaction, local identity, and low-threshold accessibility.
Urban Climate
In line with climate-resilient urban development, extensive surface unsealing is proposed. Impervious asphalt areas are to be replaced with green, permeable surfaces, while large-canopy trees will be planted throughout the street section. These measures will generate localized cooling through evapotranspiration, improve air quality, and reduce noise emissions—ultimately enhancing the environmental performance and spatial quality of the urban realm.
Biodiversity
The existing biodiversity along Johannesstraße is to be actively supported and expanded. Mycelium-based materials will be employed both as soil enhancers and design elements to improve water retention and create new habitats for urban flora and fauna. In an expanded understanding of urban inhabitants, animal species are also considered integral to the city’s ecology. Species-specific urban furniture will raise awareness for cohabitation and contribute to ecological richness.
Productive City
The proposed integration of productive uses into Johannesstraße strengthens functional diversity and enhances the spatial resilience of the urban fabric. A mycelium-based material production facility exemplifies how decentralized urban manufacturing can generate employment, foster social diversity, and cultivate a continuous human presence—contributing to a robust, everyday urbanity. Underutilized spaces are reactivated and upgraded through the insertion of productive functions into the public domain.






Process
The transformation of Johannesstraße in Stuttgart is conceived as a process-oriented, multi-scalar intervention, integrating spatial, social, and ecological dimensions. Initiated through temporary repurposing of selected parking spaces, the project introduces a gradual desealing strategy, accompanied by participatory actions in the public realm.
At its core lies an adaptive, resilient urban design approach aimed at reducing motorized traffic in favor of user-centered spatial quality. The intervention utilizes bio-based material strategies: asphalt is removed, and the substructure is layered with locally sourced organic material and inoculated with fungal mycelium. Through mycological processes, this generates a porous, moisture-retaining and climate-resilient soil structure, promoting biodiversity, improving the microclimate, and creating new urban habitats.
In parallel, a productive urban workshop is envisioned to fabricate modular elements made from mycelium composites—such as urban furniture or sports infrastructure—embedding circular design principles into the public space.
Johannesstraße thereby becomes a prototype for a connected, post-fossil urban typology, whose broader urban implications are explored through mycelium-inspired simulations on a structural level. The long-term vision for 2050 integrates mobility, urban climate, and biodiversity into a coherent, synergistic urban strategy.
The design process is non-linear and iterative, oscillating between theory and practice, materiality and social interaction—constantly redefining the relationship between human and ecological systems within the urban fabric.









LERCHENPLATZ EXAMPLE

Before

After
BREITSCHEIDPLATZ EXAMPLE

Before

After
FEUERSEEPLATZ EXAMPLE

Before

After
University:
Studio:
Project:
Support:
Students:
Semester:
Staatliche Akademie der
Bildenden Künste Stuttgart
Free Project
Master Thesis
Car-Free Johannesstrasse (Urban Shroom)
Prof. Fabienne Hoelzel
Hannes Rockenbauch
Markus Schiemann I Alisa von Postel - Project
Markus Schiemann I Niels Jakob Lorenz - Study
WS 2021 / 2022 Master
